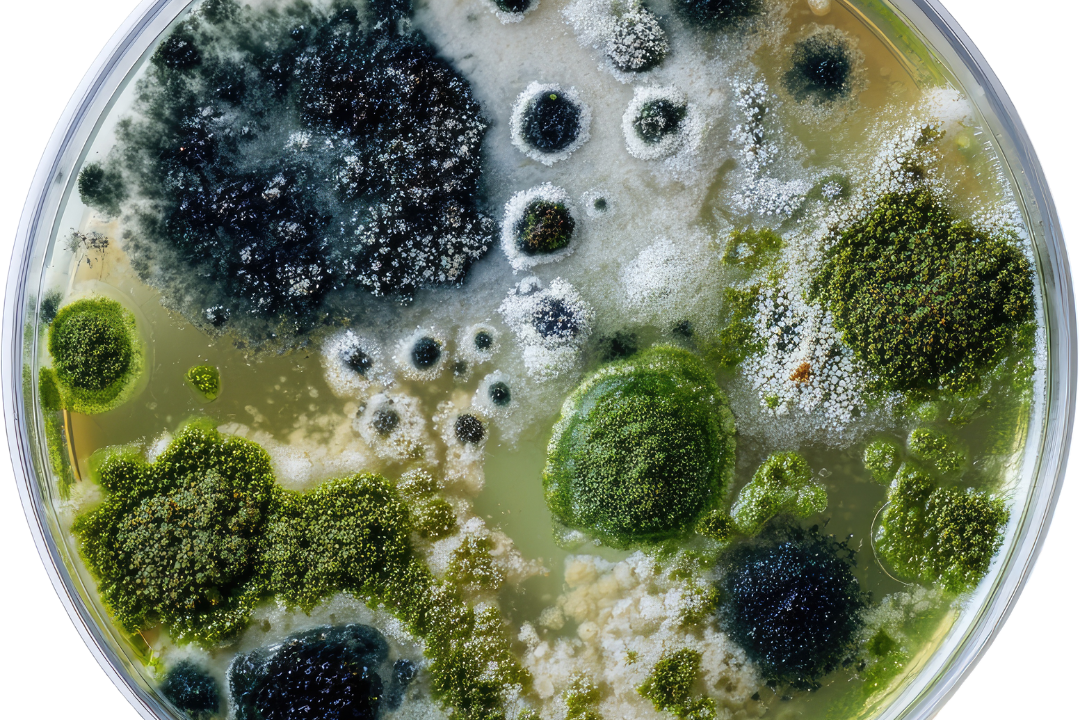
Identification d’une nouvelle cible anti-bactérienne

La maladie d’Alzheimer est la plus fréquente des démences. Aujourd’hui en France, plus d’un million de personnes sont touchées par la maladie d’Alzheimer, avec 225 000 nouveaux cas chaque année. Rappelons que la maladie d’Alzheimer apparaît le plus souvent après l’âge de 65 ans, et qu’elle est la maladie neurodégénérative la plus fréquente chez la population âgée de plus de 80 ans.
La maladie d’Alzheimer se caractérise par la présence de plaques amyloïdes dans le cerveau. Au début, la maladie se manifeste le plus souvent par des troubles de la mémoire. Ensuite, d’autres fonctions cérébrales sont touchées, avec un développement très variable selon les malades. Progressivement, avec l’évolution de la pathologie, les tâches habituelles deviennent compliquées à accomplir et l’adaptation aux situations nouvelles particulièrement difficile.
Les chercheurs ont connaissance d’un certain nombre de facteurs de risque, notamment des facteurs génétiques pré-disposants, et des facteurs d’environnement sur lesquels il est plus ou moins possible d’intervenir. Une réelle prévention de la maladie d’Alzheimer est en train de se construire.. Mais pour l’instant, il n’y a ni traitement curatif ni prévention absolue de cette maladie. Cependant, les mécanismes des processus physiopathologiques sont de mieux en mieux connus et pourraient aboutir dans quelques années à des progrès thérapeutiques significatifs. En effet, à l’Institut Pasteur de Lille, l’équipe dirigée par le Dr Jean-Charles Lambert, directeur de recherche Inserm (U1167), a coordonné 2 récentes études qui permis à la recherche de franchir un nouveau pas dans la connaissance de la génétique de la maladie, laissant entrevoir l’espoir de nouveaux outils d’aide au diagnostic, et d’une médecine personnalisée.

Des études épidémiologiques quant à elles mettent de plus en plus en évidence des facteurs associés à une diminution du déclin cognitif lié à l’âge, voire de la maladie d’Alzheimer. Ainsi, si les premiers signes sont repoussés suffisamment tardivement, nous pouvons espérer mourir sans avoir eu de symptôme de la maladie.
Pour entretenir son cerveau, il est essentiel de l’entrainer et la meilleure façon de l’entrainer est de lire, la lecture étant un élément incroyablement efficace sur notre cerveau. D’autres tâches, apparemment non-intellectuelles, par exemple le jardinage et les voyages, sont excellentes pour notre cerveau. En jardinant ou en organisant un voyage, notre cerveau anticipe l’avenir. Cette anticipation permet une conceptualisation est importante pour l’entretien de notre cerveau.
Ainsi quatre facteurs « protecteurs » sont identifiés :
- Bien voir et entendre, d’où l’importance de corriger sa vue et son audition.
- Maintenir des relations sociales et des activités intellectuelles (ordinateur, lecture, scrabble…).
- Garder une activité physique régulière sportive, ludique ou quotidienne (marche, jardinage…).
- Maintenir un poids stable et avoir une bonne alimentation :
- Riche en aliments riches en polyphénols (aux effets antioxydants) : fruits, légumes, thé, huile d’olive vierge, cacao,
- Riche en oméga 3 : poisson, fruits de mer (crustacés, mollusques) et en oléagineux (noix),
- Avec des produits laitiers fermentés (yaourts) et des œufs,
- Pour un bon microbiote grâce aux prébiotiques (topinambour, oignon, salsifis, artichaut, chicorée), céréales complètes, légumes secs,
- Modérée en aliments ultra-transformés en produits carnés et en aliments d’index glycémique élevé (pain blanc, aliments riches en glucose et en saccharose).
Tout ceci permet de mettre plus de chance de son côté. Ces bons conseils sont aussi utiles pour la prévention d’autres maladies telles que le diabète, les maladies cardiovasculaires, voire certains cancers…
Par le Docteur Jean-Michel Lecerf,
Médecin nutritionniste, spécialiste en endocrinologie et maladies métaboliques
Directeur médical du Centre Prévention Santé Longévité
Institut Pasteur de Lille
(Re)Découvrez la conférence en ligne “Maladie d’Alzheimer : de nouvelles avancées en génétique” animée par le Dr Jean-Charles Lambert, directeur de recherche Inserm à l’Institut Pasteur de Lille.
Si vous souhaitez soutenir la recherche sur la maladie d’Alzheimer à l’Institut Pasteur de Lille, rendez-vous ici.
Découvrez notre dossier thématique dédié à la maladie d’Alzheimer.